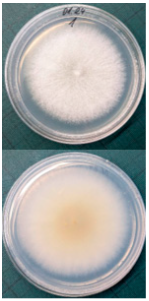
Horticulturae 10 01064 i005 Horticulturae 10 01064 i005
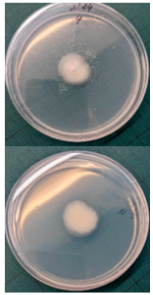
Horticulturae 10 01064 i006 Horticulturae 10 01064 i006

Abstract
The prevalence of apples as the most widely consumed fruit globally does not exempt them from storage-related issues, resulting in substantial harvest losses. A prominent concern is the development of rot due to various factors during storage. This research endeavors to examine the influence of agrotechnological methods on the longevity of apples and the incidence of rot throughout storage. Apple trees (Malus domestica Borkh. cv. Rubin) grafted on dwarfing rootstocks P60 were planted in 2010 in single rows with a spacing of 1.25 m between trees and 3.5 m between rows. Eight combinations of different growth control measures (manual, mechanical pruning, spraying, trunk cutting) were selected for the experiment. The implementation of mechanical pruning, in conjunction with trunk cutting and Ca-prohexadione spraying, as well as summer pruning, detrimentally impacted the shelf life of apples. Examination of the storage period revealed a loss of 33–40% of the crop due to rot. Conversely, manual pruning sustained a consistent level of phenolic compounds throughout the storage period. Other pruning methods resulted in a notable increase in phenolic compounds, ranging from 67% to a two-fold rise compared to the compounds present at harvest. However, the integration of mechanical pruning with subsequent manual pruning not only significantly augmented the yield of apples but also yielded a shelf life akin to that of manually pruned apples. Following the analysis of the results, it is advisable to conduct mechanical pruning of the apples intended for storage along with supplementary manual pruning.
1. Introduction
Apples rank among the most widely cultivated fruits globally. The global apple harvest in 2021 amounted to 93.1 million tons, with Europe contributing 18.4 million tons to this total []. The appeal of apples can be attributed to several key attributes, including their high nutritional value, extended shelf life, and diverse processing capabilities. High-quality harvest yields are typically reserved for direct consumption and long-term storage. Conversely, imperfect or surplus apples, such as those with non-standard sizes or those that have fallen, are earmarked for processing. There are two primary processing methods for such apples: juicing and pulp-based products like jams, purees, and apple cheeses. These processed apple products share the same beneficial properties for human health as fresh fruits [,,]. The widespread appeal of apples contributes significantly to their global popularity. Nevertheless, the length of apples’ shelf life holds particular significance for growers.
The factors affecting the fruit tree, which depend not only on the growth of the fruit tree but also on the quality of the fruit and its preservation, can be divided into three groups: genetic, agronomic, and environmental. Genetic factors include the variety and rootstock, and they determine the growth of a fruit tree and its resistance to diseases and environmental factors. Also, fruit size, color, ripening time, and even the internal composition depend on the variety and rootstock and their combination [,,,]. Environmental conditions, such as soil, temperature, precipitation, and sunlight, are also of great importance for fruit quality [,,,]. Agronomic factors are those dependent on human activity, such as training systems, watering, pruning, crop load regulation, etc. With the help of agronomic factors, it is possible to control the quantity and consistency of the harvest, the size, color, and quality of the fruits, and the spread of diseases [,,,,,].
The quality of apples changes, and yield loss is observed for various reasons during storage. The metabolism in apples does not stop even after harvesting. As a result, the composition, quality, and weight of the fruit changes. Fruit weight loss during storage is mainly attributed to water loss. Apples stored in cold conditions without additional special tools lose an average of 2–3% of their water during storage. As the internal processes continue to take place during storage, the fruits no longer receive water and nutrients from the plant, so only the available reserves are used, resulting in water loss [,,,]. Another factor that accounts for a large portion of yield loss is storage rot. Some of the most important compounds associated with rot inhibition are phenols []. Apples accumulate large amounts of phenolic compounds during growth, which continue to change in the fruit during storage. Although the spread of pathogens is also highly dependent on environmental conditions, air temperature, weather conditions, precipitation and other factors, a large proportion of apple rots are found worldwide [,,]. However, there are few major storage rots of apple: blue mold (caused by Penicillium spp.), brown rot (caused by Monilinia fructigena), bitter rot (anthracnose, caused by Colletotrichum spp.), gray mold (caused by Botrytis cinerea), Gloesporium rot or bull’s eye rot (caused by Neofabraea spp.), etc. [,,]. Also, a positive, reliable correlation was found between intact apples and calcium treatment, indicating that calcium treatment could inhibit rot pathogens [].
Most of the scientific research conducted in this area has focused on the causes of rot and the analysis of storage conditions. However, there is a lack of data on how the growing conditions impact the shelf life of apples. Therefore, the goal of this study was to examine the impact of agricultural techniques on the shelf life of apples and the incidence and severity of postharvest rot.
2. Materials and Methods
2.1. Growing Conditions
This experiment was carried out in an experimental intensive orchard in Lithuania (55.079179, 23.807503) in 2022–2023. Apple trees (Malus domestica Borkh. cv. Rubin) grafted on dwarfing rootstocks P60 were planted in 2010 in single rows with a spacing of 1.25 m between trees and 3.5 m between rows. Pest and disease management was carried out according to integrated plant protection practices, and the orchard was not irrigated. Every treatment was planted in three replicates, each comprising five individual trees. Eight agrotechnological tools were used: 1. yearly manual pruning forming slender spindles (control); 2. yearly manual pruning forming slender spindles, leaving branch stubs; 3. mechanical pruning (every two years—last pruning a year ago); 4. mechanical pruning with manual pruning every three years—last pruning in the year of harvest); 5. trunk cutting using a chainsaw + mechanical pruning (each year); 6. mechanical pruning (each year) + spraying with calcium prohexadione; 7. mechanical pruning + manual pruning + summer pruning (performed in the middle of August, removing the most vigorous and vertical shoots); and 8. mechanical pruning on one side, changing sides annually. These agrotechnical tools were applied every year from 2016 onward to the same orchard area. The main pruning (manual or mechanical depending on treatment) was carried out in February–March, depending on the outdoor temperature, when the trees were in a vegetative rest state, i.e., before the buds burst. Super spindle pruning involved leaving only weaker branches that were thinner than half the diameter of the trunk and younger than 3–4 years, while the height of the tree was maintained at up to 2.5 m. Mechanical pruning was carried out with a tractor-mounted special unit for pruning trees. Mechanical pruning only shortened the branches, and the trees were pruned in the form of a trapezoid: horizontally, at 0.7 m above ground level, the branches were cut at a distance from the trunk of 0.6 m, and at 2.5 m above ground level, the branches were cut at a distance from the trunk of 0.4 m; vertically, the trees were cut at a height of 2.5 m. Trunk cutting was performed on both sides, with one side of the trunk being cut at 20 cm above ground level and the other side of the trunk being cut at 60 cm above ground level. The first spraying with Ca-prohexadione was carried out immediately after flowering, the second was conducted at the beginning of apple maturity, and the third spraying was performed at the end of summer, with a dose of 0.9 kg ha−1. Additional summer pruning was performed in the middle of August to remove the most vigorous and vertical shoots.
2.2. Plant Material
The samples were collected from three trees in each replicate from the whole canopy using full randomization at harvest time upon commercial ripening (BBCH 87). Randomly, 15 apples were taken from one replicate, and these apples were evaluated for color level and size. Five of them were finely chopped (after removing the seed boxes with the seeds but leaving the peel), and part of the fresh material was frozen in liquid nitrogen and freeze-dried (lyophilized), while the other parts were dried for 48 h at 70 °C for elemental analysis. The dry weight/fresh weight ratio (DW/WF) was calculated. The same procedure was used to prepare plant material from apples at the end of the storage period. Only healthy apples remaining after storage were used for the sample preparation.
2.3. Assessment of Apple Rot during Storage
Ten apples from each treatment in the three replicates were subjected to storage. Apples were placed in boxes, with each replicate being stored separately, and were stored at a temperature of 3 ± 1 °C degrees for 6 months (180 days), with periodic inspection, evaluation of rotten apples, and removal of rotten fruits. After 6 months, the total number of rotten apples was established to calculate apple rot incidence, which was evaluated according to Youssef and Roberto’s [] formula with some modifications: apple rot incidence (%) = (number of rotten apples/total number of assessed apples) × 100. Apples with different rot symptoms were collected on the last day of storage. Rot samples were taken with a sterile needle and placed under a light microscope to perform visual identification according to the morphology of the spores. Secondly, samples from rot wounds were transferred onto a potato dextrose agar medium and left to grow at 22 °C in the dark. After 7 days, grown fungal colonies were investigated under a light microscope to confirm the previous visual assessment.
2.4. Total Phenolic Content Determination
Extracts were prepared by grinding 0.05 g of apples freeze-dried with liquid nitrogen and diluting this powder in 5 mL of 80% methanol. Each of the three biological replicates consisted of five apples, and the analysis was repeated in three analytical replicates.
The total content of phenolic compounds (TPC) was determined as gallic acid equivalents []. A 20 µL aliquot of the sample extract was mixed with 20 µL of 10% (w/v) Folin–Ciocalteu reagent and 160 µL of 1 M Na2CO3 solution. After incubation for 20 min in the dark, the absorbance was measured at 765 nm (Spectrostar Nano, BMG Labtech microplate reader, Ortenberg, Germany). The total content of phenolic compounds (mg g−1 DW) was calculated from the calibration curve of gallic acid (0.01–0.1 mg mL−1, R2 = 0.99).
2.5. Determination of Macro- and Microelements
The apple macro- and microelement contents were determined by means of the microwave digestion technique combined with inductively coupled plasma optical emission spectrometry (ICP-OES). Fresh randomly selected apples were cut and dried in the oven at 70 °C for 48 h. The complete digestion of dry plant material (0.2 g) was achieved with 65% HNO3 using the microwave digestion system Multiwave GO (Anton Paar GmbH, Graz, Austria). The digestion program was as follows: (1) 170 °C reached within 5 min, digested for 10 min; (2) 180 °C reached within 10 min, digested for 10 min. The mineralized samples were diluted to a volume of 50 mL with deionized water. The elemental profile was analyzed using an ICP-OES spectrometer (Spectro Genesis, SPECTRO Analytical Instruments, Kleve, Germany). The operating conditions employed for ICP-OES determination were an RF power of 1300 W, a plasma flow of 12 L min−1, an auxiliary flow of 1.0 L min−1, a nebulizer flow of 0.8 L min−1, and a sample uptake rate of 1.0 mL min−1. Calibration standards were prepared by diluting a stock multi-elemental standard solution (1000 mg L−1) in 6.5% (v/v) nitric acid and by diluting stock phosphorus and sulfur standard solutions (1000 mg L−1) in deionized water. The calibration curves for all the studied elements were in the range of 0.01–400 mg L−1.
2.6. Statistical Analysis
MS Excel Version 2010 and XLStat 2022 Data Analysis and Statistical Solution for Microsoft Excel (Addinsoft, Paris, France) were used for data processing. The data were processed via one-way analysis (ANOVA) along with the Tukey multiple comparisons test for statistical analyses, p ≤ 0.05. Three biological replicates and a conjugated sample (from five apples) were used for biochemical analysis, with three analytical replicates.
3. Results
The quality of apples changes significantly during storage (Table 1). In the study of agrotechnological measures, an average of almost 22% of apples were lost to rot during storage. Even rot-free apples lost an average of 2% of their water during the 6 months of storage, resulting in fruit wilting. Storage significantly affected not only the decrease in fruit quantity and weight but also an almost 2-fold increase in the content of phenolic compounds in apples.
Table 1.
Storage effects on apples. The data were processed using two-way analysis of variance (ANOVA) and the Tukey (HSD) test at the confidence level p = 0.05. Different letters in the same column indicate significant differences.
The effect of agrotechnological tools on apple rot incidence during storage differed up to eight times compared to manual pruning (as the control) (Table 2). The least rot-damaged apples after storage were those subjected to manual pruning alone (as the control) and mechanical pruning; when additional manual pruning was carried out in the experimental year, apple rot incidence reached about 5%. Meanwhile, mechanical pruning combined with trunk cutting increased the loss of apples during storage by 35% compared to manual pruning (as the control). Mechanical pruning combined with manual pruning significantly increased apple yield by 66% compared to manual pruning alone (as the control), but displayed the same amount of post-storage damage as the control. Mechanical pruning resulted in a significantly smaller fruit size and lower coloring level compared to manual pruning.
Table 2.
Agrotechnological tools’ effect on yield (average of three years), average fruit size and coloring, and apple rot incidence during storage (after 180 days). The data were processed using one-way analysis of variance (ANOVA) and the Tukey (HSD) test at the confidence level p = 0.05. Different letters in the same column indicate significant differences.
Different rots on apples were found and examined during the storage experiment (Table 3). The main detected rots were Gloeosporium rot and bitter rot. Several cases of Alternaria fruit spot were also found. All rots were often accompanied by blue rot caused by Penicillium spp.
Table 3.
The main apple rots detected on apples during storage.
The DW/FW ratio varied from 11.06% to 12.46% based on harvest time, and no significant differences from manual pruning were found (Table 4). After 6 months of storage, the DW/FW ratio was significantly lower in apples subjected to mechanical pruning with manual pruning in the experimental year and mechanical pruning with summer pruning compared to the control. Fruits from manually pruned (control) apple trees lost more than 2% of their water during storage, while those from trees subjected to mechanical pruning with manual pruning lost 0.7% less, representing the fruits that retained the most water during storage on a statistically significant basis. Although no significant differences in the phenolic compound content were found at harvest time, the phenolic compound content significantly differed during storage (Table 4). Manually pruned apples maintained an unchanged content of phenolic compounds during storage, while the use of other tools led to an increase in the phenolic compound content from 67% (mechanical pruning + Ca-prohexadione) up to two to three times (mechanical pruning with manual pruning) compared to apples at harvest time. All variants had significantly more phenolic compounds after storage compared to those subjected to manual pruning.
Table 4.
Effects of agrotechnological tools and storage on apples. The data were processed using one-way analysis of variance (ANOVA) and the Tukey (HSD) test at the confidence level p = 0.05. Different letters in the same column indicate significant differences.
Agrotechnological tools had an impact on the accumulation of elements in apple fruits (Table 5). Mechanical pruning on one side, changing side each time, significantly increased magnesium (Mg), potassium (K), calcium (Ca), and copper (Cu) accumulation by 12%, 20%, 16%, and 59%, respectively, compared to manual pruning. The accumulation of Cu significantly increased in all treatments with mechanical pruning compared to manual pruning.
Table 5.
Agrotechnological tools’ effects on the elements in apples. The data were processed using one-way analysis of variance (ANOVA) and the Tukey (HSD) test at the confidence level p = 0.05. Different letters in the same column indicate significant differences.
Correlation analysis revealed a significant positive relationship between potassium, magnesium, and copper (Table 6), but a negative correlation between these elements and the DW/FW ratio. A significant correlation between the Cu content in the fruit and the incidence of rot during storage was also observed. With a higher amount of accumulated copper in the fruit, a larger portion of the yield was lost due to rot during storage.
Table 6.
Correlations between the data. Values in bold are different from 0 with a significance level alpha = 0.05. Green shows a positive strong correlation, yellow highlights the correlation of apple rot with other indicators, of which orange—a strong positive correlation between rot and copper content.
After summarizing the results, the data were divided into four groups (Figure 1). The two largest groups distinguished manual pruning and mechanical pruning. The effect of mechanical pruning fell into three more groups depending on the tools used together with it. Both mechanical pruning and manual pruning, when summarized, show a similar effect regardless of the frequency of manual pruning. Meanwhile, trunk cutting was paired with unilateral pruning on alternating sides and Ca-prohexadione spraying with summer pruning. However, the strongest separation was between manual and mechanical pruning.
Figure 1.
Agglomerative hierarchy clustering (AHC) according to the agrotechnological tools’ effects. 1. Super spindle (control); 2. super spindle with long branches; 3. mechanical pruning with manual pruning one year ago (every two years); 4. mechanical pruning with manual pruning in the year of harvest; 5. mechanical pruning + manual pruning + trunk cutting by a chainsaw; 6. mechanical pruning + manual pruning + Ca-prohexadione 0.9 kg ha−1 3 times; 7. mechanical pruning + summer pruning; 8. mechanical pruning on one side, changing each time.
4. Discussion
During storage, yield is lost in various ways. One of the losses is weight loss, which is caused by water loss. Apples, on average, lose up to 3% of their water during storage in cold warehouse [,,], whereas cv. Rubin apples lost an average of less than 2% of their water in our experiment (Table 1). However, the amount of water lost is influenced by various factors. Fruit water loss during storage is affected by fruit size [,], but at the same time, fruit size is determined by growing conditions (Figure 1). According to the agrotechnological tools, water loss varied from 1.58% to 2.28% (Table 4). At the same time, the agrotechnological tools affected the DW/FW ratio in fresh apples during harvest (Table 4). During growth, fruits accumulate different amounts of water depending on growing conditions, lighting, etc. Therefore, at the beginning of storage, fruits have different ratios of dry to fresh weight, which can lead to different levels of water loss during storage [,,,,,]. During storage, fruits still perform transpiration and respiration processes, which are the main causes of the decrease in water content. As a result of this activity, the mass of the yield is reduced, but as long as only up to 3% of the water is lost, the fruits continue to be usable [,]. Meanwhile, the bigger problem is the rots that appear during storage, which destroy part of the yield. In our study, some techniques such as trunk cutting resulted in up to a 40% apple rot incidence during storage (Table 2).
Apple rot incidence depends on various factors, like the cultivar, harvest time, and, in our case, the agrotechnological tools used. Apple rots are usually divided into two categories, those that infect only through damaged areas and those that infect without damage. The most dangerous for storage are rots that infect without damage, i.e., through intact skin or even during flowering, where the infection enters the inside of the fruit through the flowers [,]. When discussing rot species, our detected rots were characteristic of the region (Table 3). Gloesporium rot is a common apple rot in Europe, including Lithuania’s neighboring countries, like Poland [] and Latvia []. Apple rots caused by Alternaria spp. are not that common in Europe; however, it is often detected in other countries []. According to the data from some studies, up to 80% of the harvest can be lost due to rots, so it is necessary to find a way to control and reduce the spread of rot [,]. Gloesporium rot is one of the most common rots, destroying a large part of the crop during storage [], and research data show that not all apple varieties are affected equally. Cv. Rubinola, which is similar to our studied cv. Rubin, has shown resistance to Gloesporium rot []. Thus, one of the ways to reduce yield losses is to choose resistant varieties, but if a variety is resistant to one rot, this does not mean that it will be resistant to other rots [,,]. Another very widespread form of rot is blue mold caused by Penicillium spp. This rot not only destroys the infected apple but also very quickly spreads to adjacent apples because it begins as soft and watery lesions of a light brown color which slowly collapse (Table 3), leading the pathogen to be transmitted to the apples in contact with the infected apple, and blue spores only appear later [,,]. Bitter rot has a similar onset, but it does not have blue spores and is not as wet as blue mold. This rot also destroys a large part of the crop; on average, 10–30% of the yield is lost due to bitter rot, but there are studies where up to 100% yield loss is recorded. This shows that the entire crop can be lost due to uncontrolled rots [,]. Another significant problem is that more and more cases of resistance in rots are being recorded, with conventional chemical means no longer being able to suppress the spread of rot. The application of agrotechnical tools could be one of the auxiliary tools helping to control the spread of rot. For example, combined sustainable plant protection systems and integrated apple-growing technologies for different cultivars of apple trees in Lithuania resulted in an average fruit yield of 39 t ha−1 in another study [].
During storage, apples not only lose water and suffer from rotting, but their metabolites also change. Some of the most important compounds associated with rot inhibition are phenols. Apples accumulate a high content of phenolic compounds during growth, which continue to change in the fruit during storage. The content of phenolic compounds in the fruit strongly depends on the apple variety, growing locations, etc. As research shows, the change in the content of phenolic compounds during storage is affected not only by storage conditions but also by the genotype [,]. Depending on the variety, the content of phenolic compounds in the fruit can vary by several or even tens of times. The content of phenolic compounds in fruits varies unevenly, depending on the variety; the content of phenolic compounds can increase faster or slower, or increase sharply after harvesting, and then decrease throughout the storage period, etc. According to Bilkova et al. [], the content of the main phenolic compounds in Rubin apples stored in cold storage increased in small amounts from harvest to 7 months of storage. The results of our study also show an increase in phenolic compound content during storage (Table 1). However, the increase in the total content of phenolic compounds was significantly influenced by the tools used to regulate the growth of fruit trees during growth (Table 4). There are studies that show that after treating apples with means containing high amounts of phenolic compounds, apple rot is stopped [,,,,]. Thus, if treatments containing more phenolic compounds reduce the number of rotting apples, it is possible that higher levels of these compounds in the fruit may suppress the spread of rot. However, for cv. Rubin, no significant correlation was found with the content of phenolic compounds either at harvest or after 6 months of storage (Table 6). This suggests that an increased content of phenolic compounds under growing conditions is not essential for rot protection. More detailed studies are needed to find out which compounds help to reduce fruit rot.
Sprays are used in various ways to protect orchards from diseases and rot. The effectiveness of some tools is based on a certain element that inhibits the pathogen [,]. One method that has been studied to reduce postharvest fruit rot is treating apples with calcium. Rademacher’s [] test results showed a reliable positive correlation between intact apples and calcium treatment. This suggests that calcium may have an inhibitory effect on rot pathogens. Ca-prohexadione is widely used around the world to regulate the growth of fruit trees [,]. However, spraying with a calcium-containing preparation did not increase the amount of calcium in the fruits (Table 5), and a higher calcium content in fruits had no significant correlation with fruit rot. Thus, calcium has a positive effect in suppressing rot and the external treatment of ripe fruits with it just before storage is recommended. Another of the most widely used elements for fruit protection is copper. Fruit trees are sprayed with copper preparations in spring, after harvest, etc. Copper is used as an effective agent to protect not only apple trees, but also other fruit trees from pathogens. Many experiments have been conducted around the world, proving the effectiveness of copper oxide, copper hydroxide, and other copper compounds [,]. However, if we look at the data from our experiment and compare the contents of these elements in these fruits and their correlation with rots, the results show that as the content of these elements in these fruits increased, the number of apples affected by copper rot also increased (Table 6). This suggests that external treatment with these element in these fruit can work in the exact opposite way to as intended. Although the external treatment of fruits with means based on various elements (zinc, calcium, copper, etc.) is an effective tool [] for protecting fruits from rots, unfortunately, the increase in the content of these elements in these fruits by agrotechnological means did not have a significant effect on rots.
Growing conditions and agrotechnological tools thus have a significant impact on the quality of the harvest (Figure 1) [,,].
5. Conclusions
Mechanical pruning, supplemented with manual pruning, not only increased apple yield by up to 66%, but also maintained a shelf life in apples similar to that of manually pruned apples, with only about a 5% loss. Furthermore, mechanical pruning substantially augmented the total phenol content by two to three times, while mitigating water loss during storage. Significantly heightened copper accumulation was observed in all instances of mechanical pruning in comparison to manual pruning treatments. Thus, after summarizing the obtained results, it can be recommended to prune apples that will be grown for storage both mechanically and manually. However, more extensive research is needed to help clarify techniques to reduce the spread of rot.
Author Contributions
Conceptualization, K.L.; methodology, K.L. and G.S.; formal analysis, K.L., I.G. and L.D.; data curation, K.L.; writing—original draft preparation, K.L. and L.D.; writing—review and editing, I.G.; supervision, G.S. All authors have read and agreed to the published version of the manuscript.
Funding
This research received no external funding.
Data Availability Statement
The original contributions presented in the study are included in the article, further inquiries can be directed to the corresponding author.
Conflicts of Interest
The authors declare no conflicts of interest.
References
- FAOSTAT. Available online: https://www.fao.org/faostat/en/#data/QCL (accessed on 1 October 2023).
- Agarwal, S.; Fulgoni, V.L., III; Welland, D. Intake of 100% fruit juice is associated with improved diet quality of adults: NHANES 2013–2016 analysis. Nutrients 2019, 11, 2513. [Google Scholar] [CrossRef] [PubMed]
- Vallée Marcotte, B.; Verheyde, M.; Pomerleau, S.; Doyen, A.; Couillard, C. Health benefits of apple juice consumption: A review of interventional trials on humans. Nutrients 2022, 14, 821. [Google Scholar] [CrossRef] [PubMed]
- Zhu, D.; Shen, Y.; Wei, L.; Xu, L.; Cao, X.; Liu, H.; Li, J. Effect of particle size on the stability and flavor of cloudy apple juice. Food Chem. 2020, 328, 126967. [Google Scholar] [CrossRef] [PubMed]
- Wang, Y.; Li, W.; Xu, X.; Qiu, C.; Wu, T.; Wei, Q.; Ma, F.; Han, Z. Progress of apple rootstock breeding and its use. Hortic. Plant J. 2019, 5, 183–191. [Google Scholar] [CrossRef]
- Marini, R.P.; Fazio, G. Apple rootstocks: History, physiology, management, and breeding. Hortic. Rev. 2018, 45, 197–312. [Google Scholar]
- Chauhan, A.; Ladon, T.; Verma, P. Strategies for rootstock and varietal improvement in apple: A review. J. Pharmacogn. Phytochem. 2020, 9, 2513–2516. [Google Scholar]
- Fazio, G. Genetics, breeding, and genomics of apple rootstocks. Apple Genome 2021, 105–130. [Google Scholar]
- Musacchi, S.; Serra, S. Apple fruit quality: Overview on pre-harvest factors. Sci. Hortic. 2018, 234, 409–430. [Google Scholar] [CrossRef]
- Mupambi, G.; Anthony, B.M.; Layne, D.R.; Musacchi, S.; Serra, S.; Schmidt, T.; Kalcsits, L.A. The influence of protective netting on tree physiology and fruit quality of apple: A review. Sci. Hortic. 2018, 236, 60–72. [Google Scholar] [CrossRef]
- Laužikė, K.; Uselis, N.; Samuolienė, G. The influence of rootstock and high-density planting on apple cv. Auksis fruit quality. Plants 2021, 10, 1253. [Google Scholar] [CrossRef]
- Kviklys, D.; Viškelis, J.; Liaudanskas, M.; Janulis, V.; Laužikė, K.; Samuolienė, G.; Uselis, N.; Lanauskas, J. Apple fruit growth and quality depend on the position in tree canopy. Plants 2022, 11, 196. [Google Scholar] [CrossRef] [PubMed]
- Mészáros, M.; Hnátková, H.; Čonka, P.; Náměstek, J. Linking mineral nutrition and fruit quality to growth intensity and crop load in apple. Agronomy 2021, 11, 506. [Google Scholar] [CrossRef]
- Kviklys, D.; Samuolienė, G. Relationships among the rootstock, crop load, and sugar hormone signaling of apple tree, and their effects on biennial bearing. Front. Plant Sci. 2020, 11, 1213. [Google Scholar] [CrossRef] [PubMed]
- Atay, E.; Crété, X.; Loubet, D.; Lauri, P.E. Effects of different crop loads on physiological, yield and fruit quality of ‘JoyaTM’apple trees: High crop load decreases maximum daily trunk diameter and does not affect stem water potential. Int. J. Fruit Sci. 2021, 21, 955–969. [Google Scholar] [CrossRef]
- Laužikė, K.; Uselis, N.; Samuolienė, G. The Influence of Agrotechnological Tools on cv. Rubin Apples Quality. Agronomy 2021, 11, 463. [Google Scholar] [CrossRef]
- Kviklys, D.; Viskelis, J.; Lanauskas, J.; Uselis, N.; Liaudanskas, M.; Janulis, V. Effects of growth control on yield and fruit quality of the apple cultivar ‘Rubin’. Agric. Food Sci. 2020, 29, 226–257. [Google Scholar]
- Valiuškaitė, A.; Uselis, N.; Kviklys, D.; Lanauskas, J.; Rasiukevičiūtė, N. The effect of sustainable plant protection and apple tree management on fruit quality and yield. Zemdirb. Agric. 2017, 104, 353–358. [Google Scholar] [CrossRef]
- Xanthopoulos, G.T.; Templalexis, C.G.; Aleiferis, N.P.; Lentzou, D.I. The contribution of transpiration and respiration in water loss of perishable agricultural products: The case of pears. Biosyst. Eng. 2017, 158, 76–85. [Google Scholar] [CrossRef]
- Tu, K.; Nicolaï, B.; De Baerdemaeker, J. Effects of relative humidity on apple quality under simulated shelf temperature storage. Sci. Hortic. 2000, 85, 217–229. [Google Scholar] [CrossRef]
- Maguire, K.M.; Banks, N.H.; Opara, L.U. Factors affecting weight loss of apples. Hortic. Rev. 2010, 25, 197–234. [Google Scholar]
- Lufu, R.; Ambaw, A.; Opara, U.L. Water loss of fresh fruit: Influencing pre-harvest, harvest and postharvest factors. Sci. Hortic. 2020, 272, 109519. [Google Scholar] [CrossRef]
- Ndubizu, T. Relations of phenolic inhibitors to resistance of immature apple fruits to rot. J. Hortic. Sci. 1976, 51, 311–319. [Google Scholar] [CrossRef]
- Calì, M.; Amaral Carneiro, G.; Cappelletti, E.; Bugiani, R.; Baschieri, T.; Baroncelli, R.; Prodi, A. First report of Colletotrichum grossum causing apple bitter rot worldwide (Italy). Plant Dis. 2023, 108, 218. [Google Scholar] [CrossRef]
- Khodadadi, F.; Giroux, E.; Bilodeau, G.J.; Jurick, W.M.; Aćimović, S.G. Genomic Resources of Four Colletotrichum Species (C. fioriniae, C. chrysophilum, C. noveboracense, and C. nupharicola) Threatening Commercial Apple Production in the Eastern United States. Mol. Plant Microbe Interact. 2023, 36, 529–532. [Google Scholar] [CrossRef] [PubMed]
- Kumari, N.; Sharma, J.N.; Singh, D.; Thakur, A.K. Major storage rots of apple: Occurrences and distribution. Int. J. Econ. Plants 2018, 5, 046–052. [Google Scholar] [CrossRef]
- Rogério, F.; Boufleur, T.R.; Ciampi-Guillardi, M.; Sukno, S.A.; Thon, M.R.; Massola Junior, N.S.; Baroncelli, R. Genome sequence resources of Colletotrichum truncatum, C. plurivorum, C. musicola, and C. sojae: Four species pathogenic to soybean (Glycine max). Phytopathology 2020, 110, 1497–1499. [Google Scholar] [CrossRef]
- Kovacevik, B.; Mitrev, S. Phenotypic and pathogenic characterization of Colletotrichum spp. associated with bitter rot on apple fruits in post-harvest storage. In Proceedings of the 2nd International Meeting Agriscience & Practice, Stip, Republic of Macedonia, 12 April 2019. [Google Scholar]
- Argenta, L.C.; de Freitas, S.T.; Mattheis, J.P.; Vieira, M.J.; Ogoshi, C. Characterization and quantification of postharvest losses of apple fruit stored under commercial conditions. HortScience 2021, 56, 608–616. [Google Scholar] [CrossRef]
- Youssef, K.; Roberto, S.R. Premature Apple Fruit Drop: Associated Fungal Species and Attempted Management Solutions. Horticulturae 2020, 6(2), 31. [Google Scholar] [CrossRef]
- Ainsworth, E.A.; Gillespie, K.M. Estimation of Total Phenolic Content and Other Oxidation Substrates in Plant Tissues Using Folin–Ciocalteu Reagent. Nature Protoc. 2007, 2, 875–877. [Google Scholar] [CrossRef]
- Konopacka, D.; Rutkowski, K.; Płocharski, W. Changes of acceptability of ‘Jonagold’ and ‘Gala’ apples during storage in normal atmosphere. J. Fruit Ornam. Plant Res. 2007, 66, 177–186. [Google Scholar] [CrossRef]
- Díaz-Pérez, J.C.; Muy-Rangel, M.D.; Mascorro, A.G. Fruit size and stage of ripeness affect postharvest water loss in bell pepper fruit (Capsicum annuum L.). HortScience 2006, 41, 68–73. [Google Scholar] [CrossRef]
- Johnston, J.W.; Hewett, E.W.; Hertog, M.L.; Harker, F.R. Harvest date and fruit size affect postharvest softening of apple fruit. J. Hortic. Sci. Biotechnol. 2002, 77, 355–360. [Google Scholar] [CrossRef]
- Baïram, E.; Lemorvan, C.; Delaire, M.; Buck-Sorlin, G. Fruit and leaf response to different source–sink ratios in apple, at the scale of the fruit-bearing branch. Front. Plant Sci. 2019, 10, 1039. [Google Scholar] [CrossRef] [PubMed]
- Faghih, S.; Zamani, Z.; Fatahi, R.; Omidi, M. Influence of kaolin application on most important fruit and leaf characteristics of two apple cultivars under sustained deficit irrigation. Biol. Res. 2021, 54. [Google Scholar] [CrossRef] [PubMed]
- Patriarca, A. Fungi and mycotoxin problems in the apple industry. Curr. Opin. Food Sci. 2019, 29, 42–47. [Google Scholar] [CrossRef]
- Grabowski, M.F. Incidence of postharvest fungal diseases of apples in integrated fruit production. Acta Sci. Pol. Hortorum Cultus 2021, 20, 123–129. [Google Scholar] [CrossRef]
- Michalecka, M.; Bryk, H.; Poniatowska, A.; Puławska, J. Identification of Neofabraea species causing bull’s eye rot of apple in Poland and their direct detection in apple fruit using multiplex PCR. Plant Pathol. 2016, 65, 643–654. [Google Scholar] [CrossRef]
- Grantina-Ievina, L. Fungi causing storage rot of apple fruit in integrated pest management system and their sensitivity to fungicides. Rural. Sustain. Res. 2015, 34, 2–11. [Google Scholar] [CrossRef]
- Sun, Y.; Lin, M.; Chen, Y.; Chen, X.; Cai, Y.; Luo, H.; Zhou, T. A study of the major pathogens causing fruit rots of apple in shelf life in Hangzhou, Zhejiang Province, China. Am. J. Plant Sci. 2019, 10, 2070. [Google Scholar] [CrossRef][Green Version]
- Schloffer, K.; Trapman, M. Hot water shower against Gloeosporium fruit rot in organic apple production-how to introduce a new system from research to practice. In Proceedings of the IOBC/WPRS Working Group “Integrated Plant Protection in Fruit Crops, Subgroup Pome Fruit Diseases”, Stellenbosch, South Africa, 24–28 November 2014; Volume 110, pp. 191–198. [Google Scholar]
- Prunier, C.; Klein, N.; Neuwald, D.A. Hot water treatment-using the apples own defence potential. In Proceedings of the 18th International Conference on Organic Fruit-Growing, Hohenheim, Germany, 19–21 February 2018; pp. 121–123. [Google Scholar]
- Gabioud Rebeaud, S.; Cotter, P.Y.; Christen, D. Ozone as an alternative method to control postharvest diseases on apples. In Proceedings of the V International Symposium on Postharvest Pathology: From Consumer to Laboratory-Sustainable Approaches to Managing Postharvest Pathogens, Liège, Belgium, 19–24 May 2019; Volume 1325, pp. 259–264. [Google Scholar]
- Ivan, E.S.; Ciceoi, R.; Jerca, I.O.; Nițu, O.A.; Stan, A. Postharvest pathology of organic apples from Romania. Preliminary study. Sci. Papers. Ser. B Hortic. 2019, Volume 63, 81–84. [Google Scholar]
- Ntasiou, P.; Myresiotis, C.; Konstantinou, S.; Papadopoulou-Mourkidou, E.; Karaoglanidis, G.S. Identification, characterization and mycotoxigenic ability of Alternaria spp. causing core rot of apple fruit in Greece. Int. J. Food Microbiol. 2015, 197, 22–29. [Google Scholar] [CrossRef] [PubMed]
- Spadaro, D.; Torres, R.; Errampalli, D.; Everett, K.; Ramos, L.; Mari, M. Pome Fruits Postharvest Pathology of Fresh Horticultural Produce; CRC Press: Boca Raton, FL, USA, 2019; pp. 55–110. [Google Scholar]
- Errampalli, D. Penicillium expansum (blue mold). In Postharvest Decay; Acadamic Press: Cambridge, MA, USA, 2014; pp. 189–231. [Google Scholar]
- Khan, I.H.; Javaid, A. Molecular characterization of Penicillium expansum associated with blue mold disease of apple in Pakistan. Pak. J. Bot. 2021, 53, 2299–2303. [Google Scholar] [CrossRef] [PubMed]
- McCulloch, M.J.; Gauthier, N.W.; Vaillancourt, L.J. First report of bitter rot of apple caused by a Colletotrichum sp. in the C. kahawae clade in Kentucky. Plant Dis. 2020, 104, 289. [Google Scholar] [CrossRef]
- Leonberger, K.; McCulloch, M.; Gauthier, N.W. Bitter Rot of Apple; Plant Pathology Fact Sheet; University of Kentucky, College of Agriculture, Food and Environment: Lexington, KY, USA, 2019. [Google Scholar]
- Lee, S.Y.; Ten, L.N.; Ryu, J.J.; Kang, I.K.; Jung, H.Y. Colletotrichum aenigma associated with apple bitter rot on newly bred cv. RubyS Apple. Res. Plant Dis. 2021, 27, 70–75. [Google Scholar] [CrossRef]
- Feng, S.; Yi, J.; Li, X.; Wu, X.; Zhao, Y.; Ma, Y.; Bi, J. Systematic review of phenolic compounds in apple fruits: Compositions, distribution, absorption, metabolism, and processing stability. J. Agric. Food Chem. 2021, 69, 7–27. [Google Scholar] [CrossRef] [PubMed]
- Vondráková, Z.; Trávníčková, A.; Malbeck, J.; Haisel, D.; Černý, R.; Cvikrová, M. The effect of storage conditions on the carotenoid and phenolic acid contents of selected apple cultivars. Eur. Food Res. Technol. 2020, 246, 1783–1794. [Google Scholar] [CrossRef]
- Bílková, A.; Baďurová, K.; Svobodová, P.; Vávra, R.; Jakubec, P.; Chocholouš, P.; Švec, F.; Sklenářová, H. Content of major phenolic compounds in apples: Benefits of ultra-low oxygen conditions in long-term storage. J. Food Compos. Anal. 2020, 92, 103587. [Google Scholar] [CrossRef]
- Łysiak, G.P.; Michalska-Ciechanowska, A.; Wojdyło, A. Postharvest changes in phenolic compounds and antioxidant capacity of apples cv. Jonagold growing in different locations in Europe. Food Chem. 2020, 310, 125912. [Google Scholar] [CrossRef]
- Lv, Y.; Tahir, I.I.; Olsson, M.E. Effect of ozone application on bioactive compounds of apple fruit during short-term cold storage. Sci. Hortic. 2019, 253, 49–60. [Google Scholar] [CrossRef]
- Rahmati-Joneidabad, M. Identification of chemical compounds of Ocimum basilicum essential oil and its effect on inhibiting the growth of fungi causing postharvest rots in apple. Res. Plant Metab. 2022, 1, 11–23. [Google Scholar]
- El Khetabi, A.; Ezrari, S.; El Ghadraoui, L.; Tahiri, A.; Ait Haddou, L.; Belabess, Z.; Merah, O.; Lahlali, R. In vitro and in vivo antifungal activities of nine commercial essential oils against brown rot in apples. Horticulturae 2021, 7, 545. [Google Scholar] [CrossRef]
- Schiavon, G.; Garello, M.; Prencipe, S.; Meloni, G.R.; Buonsenso, F.; Spadaro, D. Essential oils reduce grey mould rot of apples and modify the fruit microbiome during postharvest storage. J. Fungi 2022, 9, 22. [Google Scholar] [CrossRef] [PubMed]
- Tokaseva, D.S.; Iksat, N.N.; Omarov, R.T. Magnesium and manganese biological role in crops diseases. Bulletin of the Eurasian National University named after LN Gumilyov. Ser. Biol. Sci. 2020, 1, 31–36. [Google Scholar]
- Chatzidimopoulos, M.; Lioliopoulou, F.; Sotiropoulos, T.; Vellios, E. Efficient control of apple scab with targeted spray applications. Agronomy 2020, 10, 217. [Google Scholar] [CrossRef]
- Rademacher, W.; Kober, R. Efficient use of prohexadione-Ca in pome fruits. Eur. J. Hortic. Sci. 2003, 68, 101–107. [Google Scholar]
- Diwan, G.; Sahu, M.K.; Tiwari, S.; Ahirwar, K.; Haldar, A.; Rangare, N.R.; Banjare, K.; Kumar, S.; Ahirwar, M.; Samaiya, R.K. Effect of New Plant Growth Regulator Prohexadione-Ca on Horticultural Crops. Agric. Mech. Asia 2022, 53, 9671–9681. [Google Scholar]
- Srivastava, J.N.; Singh, A.K.; Sharma, R.K. Diseases of apples and their management. In Diseases of Fruits and Vegetable Crops; Apple Academic Press: Palm Bay, FL, USA, 2020; pp. 19–39. [Google Scholar]
- Behlau, F.; Lanza, F.E.; da Silva Scapin, M.; Scandelai, L.H.M.; Silva Junior, G.J. Spray volume and rate based on the tree row volume for a sustainable use of copper in the control of citrus canker. Plant Dis. 2021, 105, 183–192. [Google Scholar] [CrossRef]
- Garton, W.J.; Mazzola, M.; Alexander, T.R.; Miles, C.A. Efficacy of fungicide treatments for control of anthracnose canker in young cider apple trees in Western Washington. HortTechnology 2019, 29, 35–40. [Google Scholar] [CrossRef]
Disclaimer/Publisher’s Note: The statements, opinions and data contained in all publications are solely those of the individual author(s) and contributor(s) and not of MDPI and/or the editor(s). MDPI and/or the editor(s) disclaim responsibility for any injury to people or property resulting from any ideas, methods, instructions or products referred to in the content. |
© 2024 by the authors. Licensee MDPI, Basel, Switzerland. This article is an open access article distributed under the terms and conditions of the Creative Commons Attribution (CC BY) license (https://creativecommons.org/licenses/by/4.0/).